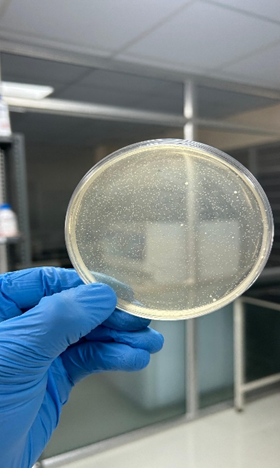
image.png

Log 12 Pro Biotech
Enhancing gut health
OUR SCIENCE
NEXT Generation probiotics
​
At LOG12 ProBiotech, we are pioneering the development of next-generation probiotics,
including Akkermansia muciniphila and Faecalibacterium prausnitzii, leveraging cutting-edge
microbiome science to deliver clinically validated health benefits.
Our early research and ongoing trials have demonstrated promising results, positioning LOG12 Probiotech
as a leader in precision probiotic innovation and a key driver of the future of global health solutions.

Next-generation probiotics (NGPs) represent an advanced class of probiotics that extend beyond traditional strains like Lactobacillus and Bifidobacterium. These are novel microbial strains or consortia selected for their ability to influence human health in highly targeted ways, often addressing specific diseases, metabolic pathways, or immune responses. Unlike conventional probiotics, NGPs are developed primarily for therapeutic or high-value health applications.
​
Key characteristics of NGPs include:
-
Novel Strains: Frequently isolated from the human gut microbiome rather than traditional fermented foods.
-
Mechanism-Based Selection: Targeted for specific functions such as anti-inflammatory activity, pathogen inhibition, or beneficial metabolite production.
-
Precision Health Applications: Designed for conditions such as obesity, metabolic syndrome, inflammatory bowel disease, skin disorders, and oral health.
-
Inclusion of Non-Traditional Species: Strains like Faecalibacterium prausnitzii, Akkermansia muciniphila are being explored.
-
Enhanced Functional Outcomes: Often combined with prebiotics or postbiotics to improve colonization, activity, and efficacy.
Through these innovations, LOG12 Biotech is advancing the next frontier of microbiome-based therapeutics, delivering precision probiotic solutions with the potential to transform human health on a global scale.
​
Syn biotics
At LOG12 ProBiotech, we are developing advanced synbiotic solutions that integrate cutting-edge probiotic strains with tailored prebiotics to maximize efficacy and unlock new opportunities in global health and wellness
Synbiotics are innovative formulations that combine probiotics—live beneficial microorganisms—with prebiotics, the selective substrates that promote their growth and activity. By delivering both the microbial strains and their preferred nutrients in a single product, synbiotics enhance colonization, functional efficacy, and the production of health-promoting metabolites.
Key advantages of synbiotics include:
-
Enhanced Gut Colonization: Prebiotics selectively support the survival and activity of administered probiotic strains.
-
Optimized Microbiome Modulation: The combination improves microbial balance, promoting beneficial interactions and inhibiting pathogens.
-
Broad Health Applications: Synbiotics support gut barrier integrity, immune function, metabolic regulation, oral health, and even skin wellness.
-
Next-Generation Potential: When paired with next-generation probiotics like Akkermansia muciniphila or Faecalibacterium prausnitzii, synbiotics can deliver precision-targeted, clinically relevant outcomes.